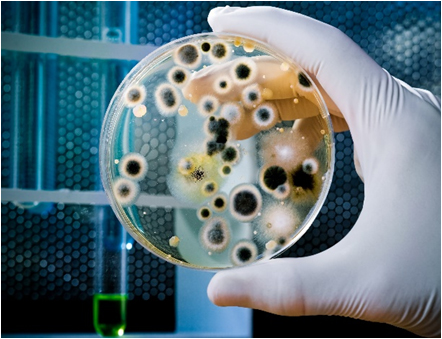
Mold Remediation and Mold Removal

Mold Remediation and Mold Removal
We Are Mold remediation experts! We offer our five step mold removal process. Don’t be misled or overcharged. All our references are great references. We have great references because we have several methods to deal with mold removal, and have successfully remediated and passed clearance testing on hundreds of projects ranging from home owners to building owners to county and state owned properties.
Dade Mold Inspectors will prepare a professional estimate free of charge detailing the scope of work and how long it will take to be completed. We guarantee expert service at up to 50% less than other companies charge. Mold Damage, Mold Damage Spreads through wall.